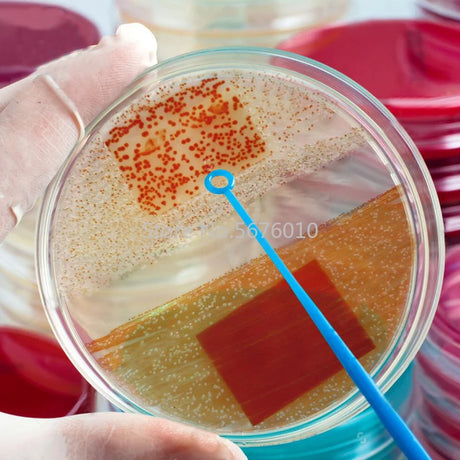

- Sale
Plastic Automatic Indoor/Outdoor Plant Water Feeder.
$997 USD$1297Unit price /Unavailable - Sale
Plastic Disposable Petri Dish 10pieces/pack 35mm, 60mm, 90mm, 100mm, 120mm Or 150mm
From $1397 USD$1797Unit price /Unavailable - Sale
Plastic Key Clips For Backpacks Or Handbags
From $1097 USD$1397Unit price /Unavailable - Sold outSale
Plastic Knitting/Weaving Loom With Long Handle Crochet Hook.
$1797 USD$2297Unit price /Unavailable - Sold outSale
Plastic Lid For Boxed Milk And Juice Seals For Freshness And Easy to Pour
$1097 USD$1497Unit price /Unavailable - Sale
Plastic Lunch Bento OR Storage Food Box With Seal Proof Lid.
$1197 USD$1597Unit price /Unavailable - Sold outSale
Plastic Moisture-Proof Bag Clips
$1197 USD$1597Unit price /Unavailable - Sold outSale
Plastic multi-port support hangers for Clothes.
From $1097 USD$1497Unit price /Unavailable - Sold outSale
Plastic Rice Bowl Strainer/ Vegetable Colander Basket With Handles
$1097 USD$1497Unit price /Unavailable - Sale
Plastic Transparent Shaver Case For Travel.
$1097 USD$1397Unit price /Unavailable - Sale
Plastic Wall Mounted Storage Boxes.
$1197 USD$1597Unit price /Unavailable - Sold outSale
Plastic/Waterproof Playing Card Collection.
$1297 USD$1697Unit price /Unavailable - Sold outSale
Play Dough Plastic Cutters And Mould Sets.
From $997 USD$1297Unit price /Unavailable - Sold outSale
Playing Cards Electric Automatic Shuffler
From $2897 USD$3497Unit price /Unavailable - Sold outSale
Plug In LED Motion Sensor Night Light.
$1197 USD$1597Unit price /Unavailable - Sale
Plus Size Silk Rayon Nightgown/ Bathrobe.
$2097 USD$2597Unit price /Unavailable